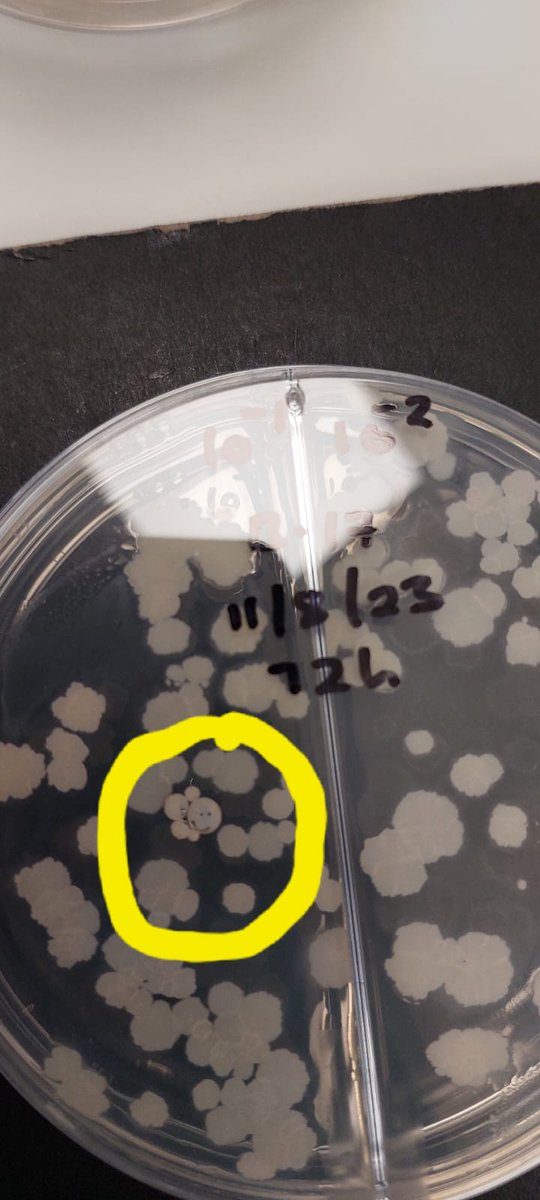
🦠🔍 During one of our experiments, we stumbled upon this charming bacterial colony that couldn't resist showing off its best smiley face! Sometimes, even the simplest experiments can lead to the coolest results. So, stay curious, and keep exploring! 😊🧪#MicrobialArtistry

Vuyo Lab
@vuyolab
Tuberculosis, Cancer, Drug discovery, Extremophiles (South African Medical Research Council/Stellenbosch University Medical School).
ID: 1133885183416066048
http://vuyomavlab.com/ 29-05-2019 23:57:49
40 Tweet
58 Followers
136 Following


Our colleague, Dr Liezel Smith, representing the Centre of Excellence for Biomedical TB Research at the first official National Research Foundation of South Africa CoE Science Engagament Seminar hosted by SciSTIP and SciCOM at CREST. @dsigovza SAASTA SU, Faculty of Medicine and Health Sciences Stellenbosch University




#Cannabis has long been used as medicine for centuries, well sometimes, illegally. Ricquelle here will investigate the plant's potential as an anti-TB drug candidate using some novel experiments. We promised Division of Molecular Biology and Human Genetics and SU, Faculty of Medicine and Health Sciences not to vaporize the plants 😀🚭












The Oceans - Our future pharmacies Recognizing the value of community engagement, the VuyoLab met with the Kleinbaai community at Marine Dynamics' Marine Evening (06/09/22) to discuss the continued importance of preserving oceans. Read more >> dict.org.za/blog/the-ocean…